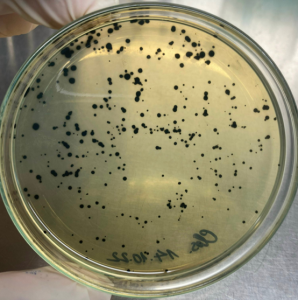
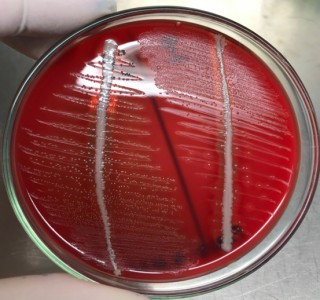

THƯ VIỆN ẢNH
1. Hình thái Gram Bacillus megaterium

2. Hình thái Gram Bacillus cereus

3. Hình thái gram Haemophilus parasuis

4. Hình thái nhuộm gram Streptococcus suis

5. Hình thái nhuộm gram ORT

6. Hình ảnh phân lập vi khuẩn Clostridium perfingens
7. Hình ảnh phân lập vi khuẩn Actinobacillus pleuropneumoniae